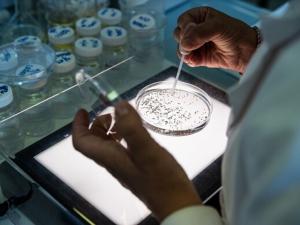
Laboratorio di chimica - Analisi dell'acqua

Body
Dalla Galleria Pavoncelli all’impianto di potabilizzazione del Pertusillo, dal depuratore di Monopoli al Laboratorio chimico centrale di Bari, passando per la posa in opera di alcune condotte in un centro abitato della regione, una carrellata di immagini sui luoghi-simbolo di Acquedotto Pugliese. Uno spaccato delle molteplici e complesse attività in cui è impegnata la nostra azienda, con l’obiettivo di portare nelle case dei pugliesi ogni giorno un’acqua buona, pulita e sicura.